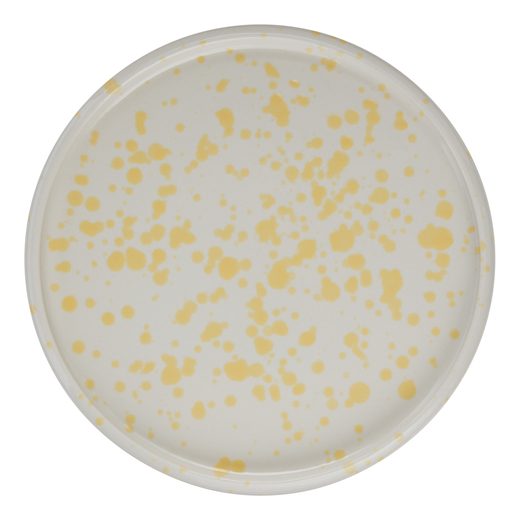
000000001000510896-2

BOOGY SPLASH
tányér sárga Ø 21 cm
2 990 Ft
Cikkszám: 000000001000510896
ELÉRHETŐSÉG: készleten, szállítás 2-5 munkanap
WEBSHOP KÉSZLET:
11 db
Több terméket raktál a kosaradba, mint amennyi jelenleg raktárunkban megtalálható. A kívánt mennyiséget központi raktárunkból tudjuk megrendelni neked. A szállítási idő így 2-3 hétre növekszik.
Élénk pettyek táncolnak a Boogy Splash reggelizőtányéron. A minimalista, kiváló minőségű kőedény étkészlet organikus formáival és modern, frisbee‑szerű íveivel igazán különleges megjelenést ad az asztalnak. A letisztult színvilág és a karakteres design miatt a Boogy Splash tányérok és tálak igazi statement darabok a terítékben. Többféle színben kapható, így könnyedén összeállíthatod a saját Mix & Match kombinációdat.